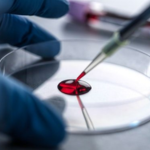

Accurate Testing for Confident Care

At Rejoint Ortho Care, we offer comprehensive, dependable, and accurate blood testing services to support your overall healthcare and orthopaedic needs. Whether you require routine blood work, diagnostic screenings, or specialized tests, our goal is to provide fast, reliable results with the highest level of safety and care. With advanced equipment and skilled lab technicians, we ensure every test is handled with precision for better diagnosis and effective treatment planning.
We provide a wide range of tests, from routine panels to specialized hormone, vitamin, and disease markers, offering accurate health insights at convenient, affordable pricing.
For added comfort, we offer home sample collection services based on test type and technician availability, making testing easier for patients with mobility or time constraints.
Your test results can be shared online or via WhatsApp, allowing you to conveniently view and store your reports on your phone or computer without visiting the clinic.
We understand the importance of timely diagnosis. Most of our test results are processed and delivered within 24–48 hours, helping your doctor begin the right treatment without delay.
Our trained and certified lab technicians ensure safe sample collection, hygienic handling, and a comfortable testing experience from start to finish.

We provide a wide range of tests including routine blood panels, cholesterol tests, vitamin levels, hormone profiles, inflammatory markers, and disease-specific screenings.
Most of our blood test results are delivered within 24–48 hours, depending on the type of test.
Yes. Home collection is available based on the test requirements and technician availability. You can book it in advance.
Reports can be shared digitally via WhatsApp or email, making it easy for you to view and store them.
Absolutely. All blood tests are handled by experienced, certified lab technicians to ensure safe, hygienic, and accurate testing.